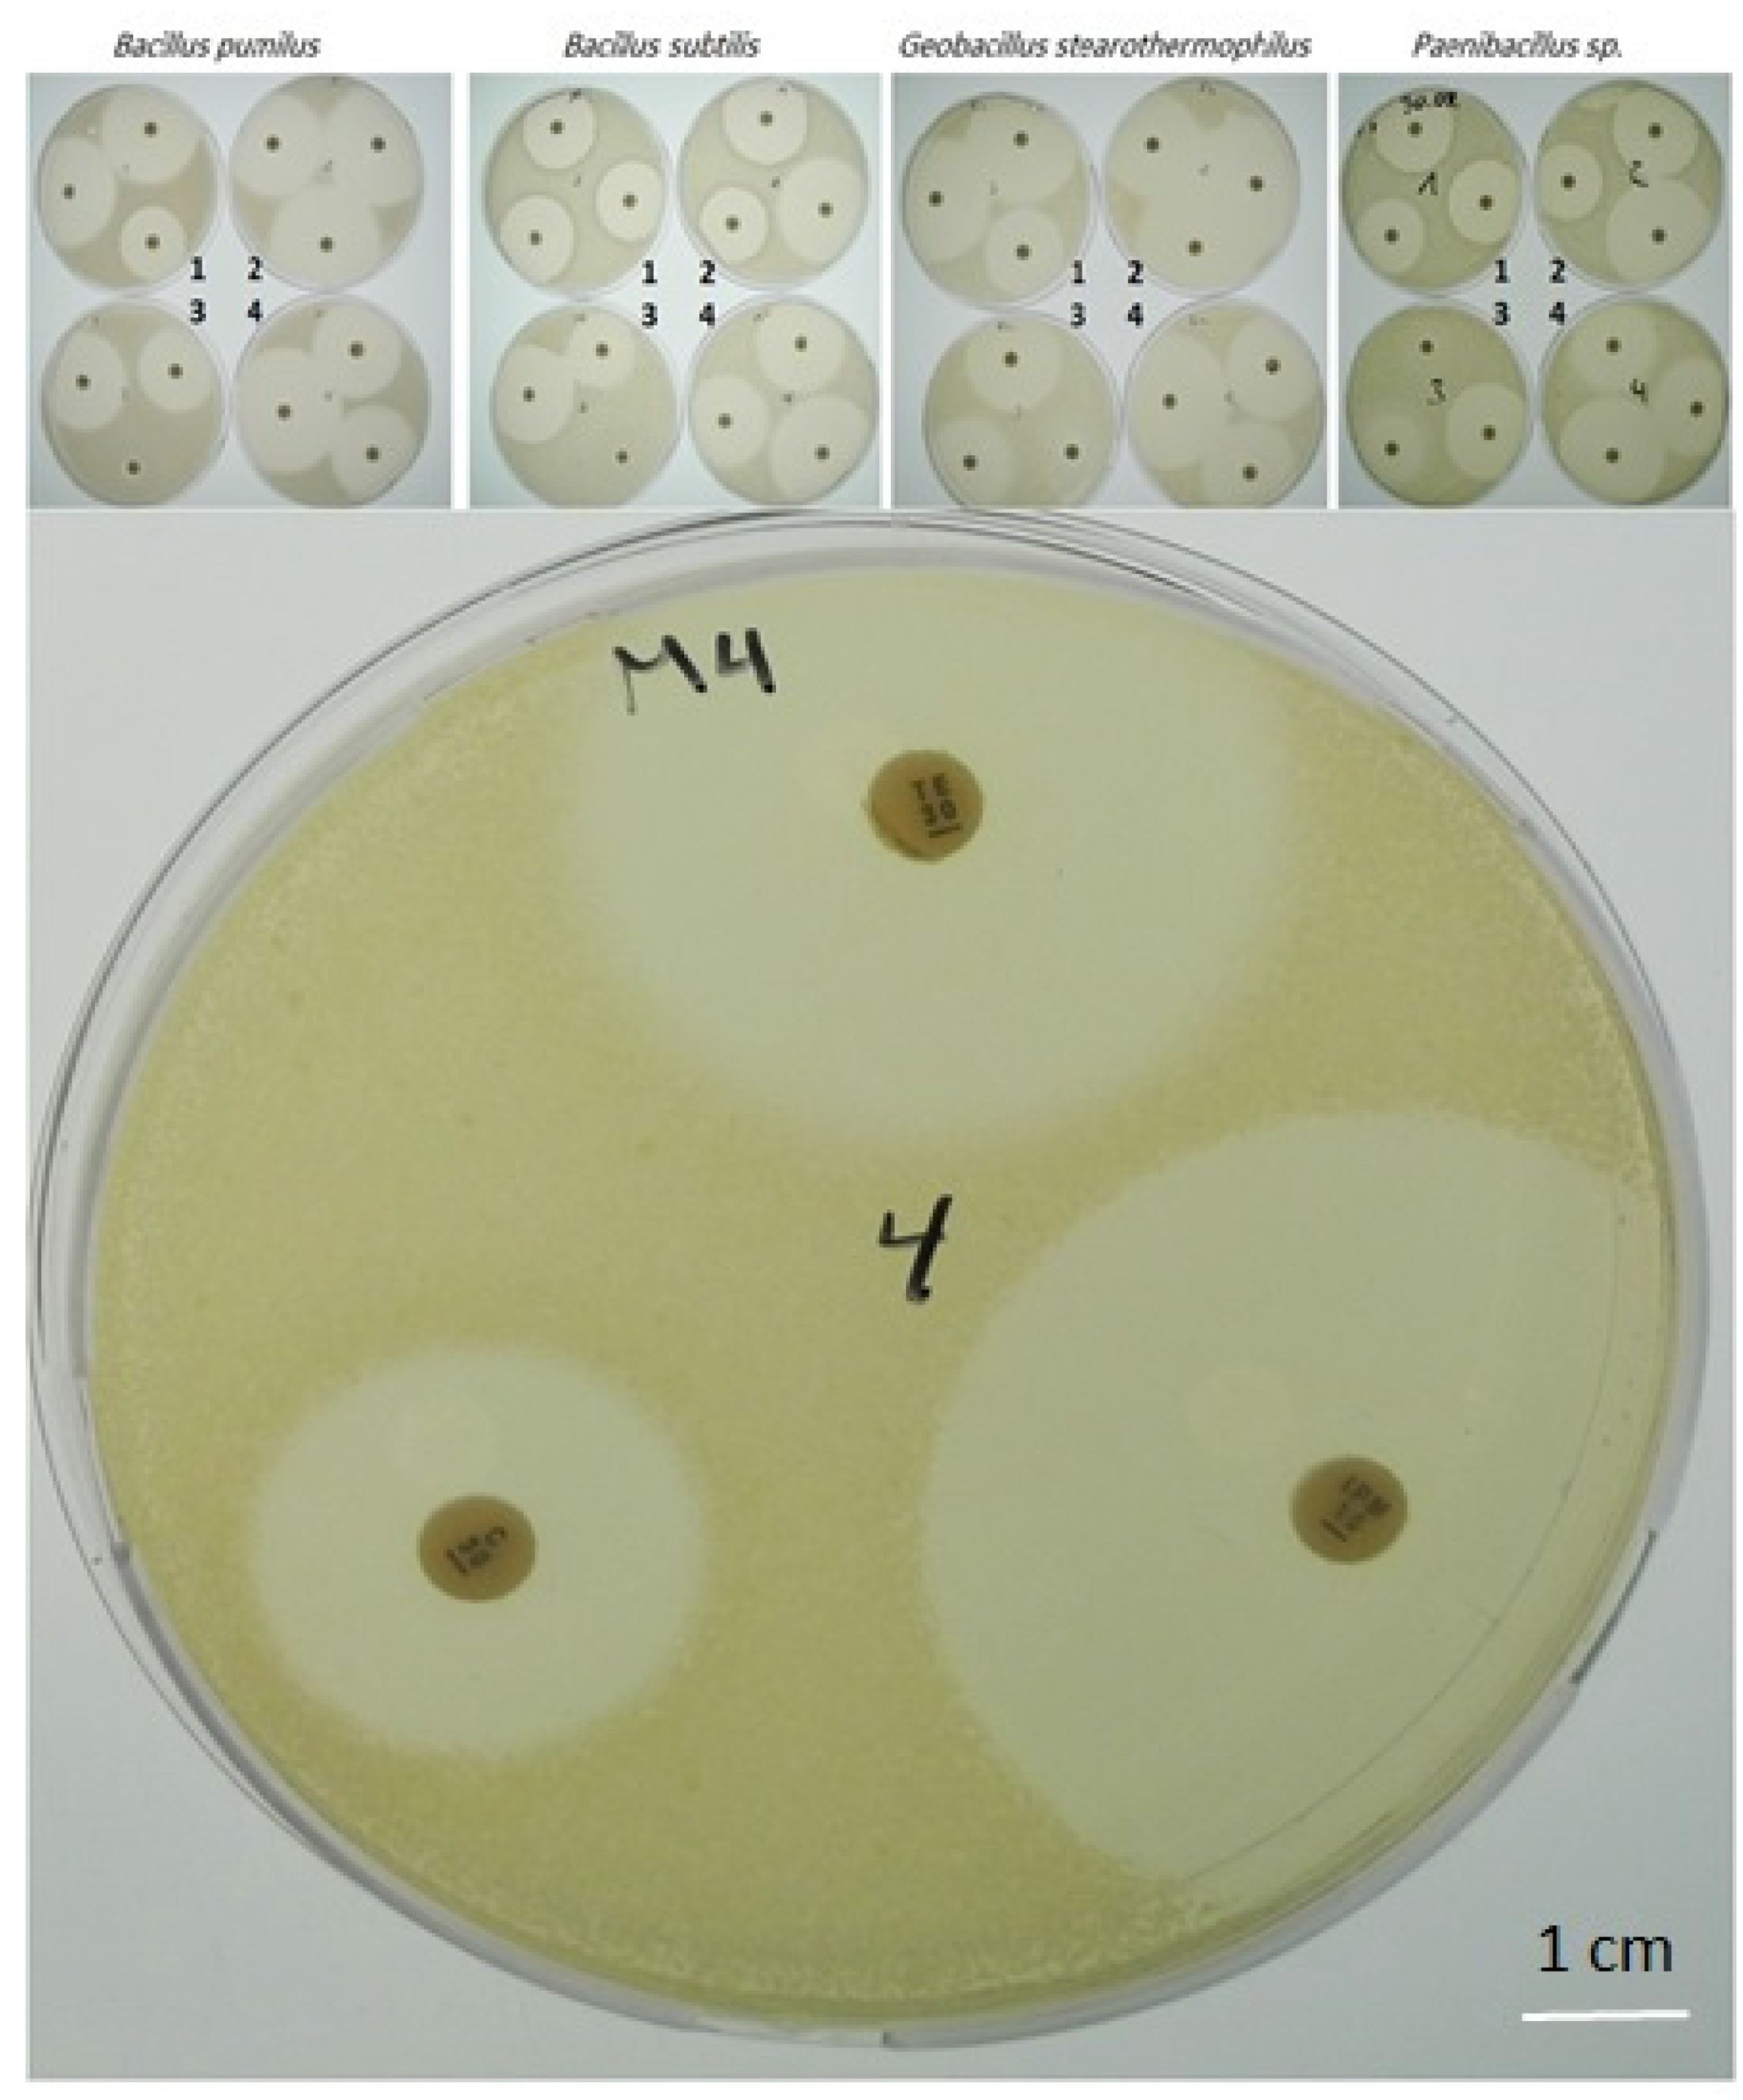
Horticulturae 07 00526 g004 Horticulturae 07 00526 g004

Endophytic Bacteria in Banana In Vitro Cultures: Molecular Identification, Antibiotic Susceptibility, and Plant Survival
Abstract
1. Introduction
2. Materials and Methods
2.1. Plant Material and Growth Conditions
2.2. Isolation of Contaminants, Microbial Growth Media and Microscopic Observations
2.3. Fatty acid Methyl Ester (FAME) Analysis
2.4. Total DNA Extraction, PCR Conditions and Sequencing
2.5. Antibiotic Susceptibility of the Bacteria
2.6. Antibiotic Treatment to Prevent Contamination in Banana Shoot Cultures
2.7. Experimental Design and Statistical Analysis
3. Results and Discussion
3.1. Isolation, Morphological and Biochemical Analyses of Bacterial Isolates
3.2. Sequencing Analyses of 16S rDNA, GyrA and GyrB Genes
3.3. Antibiotic Susceptibility and Side Effects on Banana In Vitro Cultures
4. Conclusions
Author Contributions
Funding
Institutional Review Board Statement
Informed Consent Statement
Data Availability Statement
Acknowledgments
Conflicts of Interest
References
- Kałużna, M.; Mikiciński, A.; Sobiczewski, P.; Zawadzka, M.; Zenkteler, E.; Orlikowska, T. Detection, isolation, and preliminary characterization of bacteria contaminating plant tissue cultures. Acta Agrobot. 2014, 66, 81–92. [Google Scholar] [CrossRef]
- Nadha, H.K.; Salwan, R.; Kasana, R.C.; Anand, M.; Sood, A. Identification and elimination of bacterial contamination during in vitro propagation of Guadua angustifolia Kunth. Pharmacogn. Mag. 2012, 8, 93–97. [Google Scholar]
- Guan, S.H.; Sattler, I.; Lin, W.H.; Guo, D.A.; Grabley, S. p-Aminoacetophenonic acids produced by a mangrove endophyte: Streptomyces griseus subspecies. J. Nat. Prod. 2005, 68, 1198–1200. [Google Scholar] [CrossRef]
- Danso, K.E.; Azu, E.; Elegba, W.; Asumeng, A.; Amoatey, H.M.; Klu, G.Y.P. Effective decontamination and subsequent plantlet regeneration of sugarcane (Sacchrum officinarum L.) in vitro. Int. J. Integr. Biol. 2011, 11, 90–96. [Google Scholar]
- Ganen, S.T.S.; Nietsche, S.; Pereira, M.C.T.; Reis, S.T.; Xavier, A.A.; Santos, T.M.; Fernandes, T.P. Microbial contamination in explants of banana cultivars ‘Galil 18’ and ‘Tropical’. Acta Hortic. 2009, 829, 341–344. [Google Scholar] [CrossRef]
- Guns, V.J.; Swennen, R. Bacterial contamination in Musa shoot tip cultures. Acta Hort. 1998, 490, 485–492. [Google Scholar]
- Martínez, L.; Caballero-Mellado, J.; Orozco, J.; Martínez-Romero, E. Diazotrophic bacteria associated with banana (Musa spp.). Plant Soil 2003, 257, 35–47. [Google Scholar] [CrossRef]
- Souza, S.A.; Xavier, A.A.; Costa, M.R.; Cardoso, A.; Pereira, M.C.; Nietsche, S. Endophytic bacterial diversity in banana ‘Prata Anã’ (Musa spp.) roots. Genet. Mol. Biol. 2013, 36, 252–264. [Google Scholar] [CrossRef] [PubMed]
- Thomas, P.; Swarna, G.K.; Patil, P.; Rawal, R.D. Ubiquitous presence of normally non-culturable endophytic bacteria in field shoot-tips of banana and their gradual activation to quiescent cultivable form in tissue cultures. Plant Cell Tissue Organ Cult. (PCTOC) 2008, 93, 39–54. [Google Scholar] [CrossRef]
- Ting, A.S.Y.; Meon, S.; Kadir, J.; Radu, S.; Singh, G. Endophytic microorganisms as potential growth promoters of banana. BioControl 2007, 53, 541–553. [Google Scholar] [CrossRef]
- Huys, G.; Vanhoutte, T.; Joossens, M.; Mahious, A.S.; De Brandt, E.; Vermeire, S.; Swings, J. Coamplification of Eukaryotic DNA with 16S rRNA Gene-Based PCR Primers: Possible Consequences for Population Fingerprinting of Complex Microbial Communities. Curr. Microbiol. 2008, 56, 553–557. [Google Scholar] [CrossRef]
- Karen, C.C.; Robin, P. Systems for identification if bacteria and fungi. In Manual of Clinical Microbiology; James, H.J., Michael, A.P., Karen, C.C., Guido, F., Marie, L.L., Sandra, S.R., David, W.W., Eds.; American Society for Microbiology: Washington, DC, USA, 2015; pp. 29–43. [Google Scholar]
- Grahn, N.; Olofsson, M.; Ellnebo-Svedlund, K.; Monstein, H.-J.; Jonasson, J. Identification of mixed bacterial DNA contamination in broad-range PCR amplification of 16S rDNA V1 and V3 variable regions by pyrosequencing of cloned amplicons. FEMS Microbiol. Lett. 2003, 219, 87–91. [Google Scholar] [CrossRef]
- Szewczyk-Taranek, B.; Jaglarz, A.; Pałka, P.; Supel, P.; Kaszycki, P.; Mazur, J.; Pawłowska, B. Identification and control of endophytic bacteria during in vitro cultures of Staphylea pinnata L. Folia Hortic. 2020, 32, 47–55. [Google Scholar] [CrossRef]
- Spina, R.; Saliba, S.; Dupire, F.; Ptak, A.; Hehn, A.; Piutti, S.; Poinsignon, S.; Leclerc, S.; Bouguet-Bonnet, S.; Laurain-Mattar, D. Molecular identification of endophytic bacteria in Leucojum aestivum in vitro culture, NMR-based metabolomics study and LC-MS analysis leading to potential Amaryllidaceae alkaloid production. Int. J. Mol. Sci. 2021, 22, 1773. [Google Scholar] [CrossRef] [PubMed]
- Ali, M.; Ahmad, Z.; Ashraf, M.F.; Dong, W. Maize endophytic microbial-communities revealed by removing PCR and 16S rRNA sequencing and their synthetic applications to suppress maize banded leaf and sheath blight. Microbiol. Res. 2020, 242, 126639. [Google Scholar] [CrossRef] [PubMed]
- Valerio, F.; De Bellis, P.; Di Biase, M.; Lonigro, S.; Giussani, B.; Visconti, A.; Lavermicocca, P.; Sisto, A. Diversity of spore-forming bacteria and identification of Bacillus amyloliquefaciens as a species frequently associated with the ropy spoilage of bread. Int. J. Food Microbiol. 2012, 156, 278–285. [Google Scholar] [CrossRef] [PubMed]
- Kacar, Y.A.; Faber, B. Micropropagation of Banana. In Plant Cell Culture Protocols, 3rd ed.; Loyola-Vargas, V.M., Ochoa-Alejo, N., Eds.; Springer: Berlin/Heidelberg, Germany, 2012; pp. 140–151. [Google Scholar]
- Murashige, T.; Skoog, F. A revised medium for rapid growth and bioassays with tobacco tissue cultures. Physiol. Plant. 1962, 15, 473–497. [Google Scholar] [CrossRef]
- Miller, L.T. A single derivatization method for bacterial fatty acid methyl esters including hydroxy acids. J. Clin. Microbiol. 1982, 16, 584–586. [Google Scholar] [CrossRef]
- Kuykendall, L.D.; Roy, M.A.; O’Neill, J.J.; Devine, T.E. Fatty Acids, Antibiotic Resistance, and Deoxyribonucleic Acid Homology Groups of Bradyrhizobium japonicum. Int. J. Syst. Bacteriol. 1988, 38, 358–361. [Google Scholar] [CrossRef]
- Lane, D.J. rRNA sequencing. In Nucleic Acid Techniques in Bacterial Systematics; Stackebrandt, E., Goodfellow, M., Eds.; Wiley: New York, NY, USA, 1991; Volume 5, pp. 115–175. [Google Scholar]
- Kurtzman, C.P.; Robnett, C.J. Identification and phylogeny of ascomycetous yeasts from analysis of nuclear large subunit (26S) ribosomal DNA partial sequences. Antonie Van Leeuwenhoek 1998, 73, 331–371. [Google Scholar] [CrossRef]
- Meier-Kolthoff, J.P.; Göker, M.; Spröer, C.; Klenk, H.P. When should a DDH experiment be mandatory in microbial taxonomy? Arch. Microbiol. 2013, 195, 413–418. [Google Scholar] [CrossRef]
- Meier-Kolthoff, J.P.; Auch, A.F.; Klenk, H.-P.; Göker, M. Genome sequence-based species delimitation with confidence intervals and improved distance functions. BMC Bioinform. 2013, 14, 60. [Google Scholar] [CrossRef]
- Meier-Kolthoff, J.P.; Carbasse, J.S.; Peinado-Olarte, R.L.; Göker, M. TYGS and LPSN: A database tandem for fast and reliable genome-based classification and nomenclature of prokaryotes. Nucleic Acids Res. 2021, gkab902. [Google Scholar] [CrossRef]
- The European Committee on Antimicrobial Susceptibility Testing. EUCAST Disk Diffusion Test Manual. v 7.0. January 2019. Available online: http://www.eucast.org (accessed on 26 October 2021).
- Kunitsky, C.; Osterhout, G.; Sasser, M. Identification of microorganisms using fatty acid methyl ester (FAME) analysis and the MIDI Sherlock Microbial Identification System. Encycl. Rapid Microbiol. Methods 2006, 3, 1–8. [Google Scholar]
- Dias, A.C.F.; Costa, F.E.C.; Andreote, F.D.; Lacava, P.T.; Teixeira, M.A.; Assumpção, L.C.; Araújo, W.L.; Azevedo, J.L.; Melo, I.S. Isolation of micropropagated strawberry endophytic bacteria and assessment of their potential for plant growth promotion. World J. Microbiol. Biotechnol. 2009, 25, 189–195. [Google Scholar] [CrossRef]
- Odutayo, O.I.; Oso, R.T.; Akinyemi, B.O.; Amusa, N.A. Microbial contaminants of cultured Hibiscus cannabinus and Telfaria occidentalis tissues. Afr. J. Biotechnol. 2004, 3, 473–476. [Google Scholar] [CrossRef][Green Version]
- Leifert, C.; Waites, W.M. Dealing with microbial contaminants in plant tissue and cell culture: Hazard analysis and critical control points. In Physiology, Growth, and Development of Plants; Lumsden, P.J., Nicholar, J.R., Davies, W.J., Eds.; KIuwa Academic Published: The Netherlands, 1994; pp. 363–378. [Google Scholar]
- Sige, D.C. Bacteria as plant pathogens. In Bacterial Plant Pathology: Cell and Molecular Aspects; Sigee, D.C., Ed.; Cambridge University Press: Cambridge, UK, 1993; pp. 1–12. [Google Scholar]
- Gunson, H.E.; Spencer-Phillips, P.T.N. Latent bacterial infections: Epiphytes and endophyres as contaminants of micropropagated plants. In Physiology, Growth and Development of Plants in Culture; Nicholas, J.R., Ed.; Kluwer Academic Publishers: Dordrecht, The Netherlands, 1994; pp. 379–396. [Google Scholar]
- Leifert, C.; Morris, C.E.; Waites, W.M. Ecology of Microbial Saprophytes and Pathogens in Tissue Culture and Field-Grown Plants: Reasons for Contamination Problems In Vitro. Crit. Rev. Plant Sci. 1994, 13, 139–183. [Google Scholar] [CrossRef]
- Podwyszyńska, M.; Hempel, M. Identification and elimination of “slowly growing” bacteria from a micropropagated Gerbera. Acta Hortic. 1987, 212, 112. [Google Scholar] [CrossRef]
- Weisburg, W.G.; Barns, S.M.; Pelletier, D.A.; Lane, D.J. 16S ribosomal DNA amplification for phylogenetic study. J. Bacteriol. 1991, 173, 697–703. [Google Scholar] [CrossRef] [PubMed]
- Hugenholtz, P. Exploring prokaryotic diversity in the genomic era. Genome Biol. 2002, 3, REVIEWS0003. [Google Scholar] [CrossRef] [PubMed][Green Version]
- Luna, C.; Collavino, M.; Mroginski, L.; Sansberro, P. Identification and control of bacterial contaminants from Ilex dumosa nodal segments culture in a temporal immersion bioreactor system using 16S rDNA analysis. Plant Cell Tissue Organ Cult. (PCTOC) 2008, 95, 13–19. [Google Scholar] [CrossRef]
- Fang, J.-Y.; Hsu, Y.-R. Molecular identification and antibiotic control of endophytic bacterial contaminants from micropropagated Aglaonema cultures. Plant Cell Tissue Organ Cult. (PCTOC) 2012, 110, 53–62. [Google Scholar] [CrossRef]
- Thomas, P.; Swarna, G.K.; Roy, P.K.; Patil, P. Identification of culturable and originally non-culturable endophytic bacteria isolated from shoot tip cultures of banana cv. Grand Naine. Plant Cell Tissue Organ Cult. (PCTOC) 2008, 93, 55–63. [Google Scholar] [CrossRef]
- Kneifel, W.; Leonhardt, W. Testing of different antibiotics against Gram-positive and Gram-negative bacteria isolated from plant tissue culture. Plant Cell Tissue Organ Cult. (PCTOC) 1992, 29, 139–144. [Google Scholar] [CrossRef]
- Birmeta, G.; Passoth, V.; Roos, S.; Welander, M. Identification of bacteria and yeasts from in vitro and surface-sterilized field samples of Ensete ventricosum by rDNA analysis. Biotechnol. Lett. 2004, 26, 1867–1872. [Google Scholar] [CrossRef] [PubMed]
- Cassells, A.C. Problems in tissue culture: Culture contamination. In Micropropagation; Debergh, P.C., Zimmerman, R.H., Eds.; Springer: Dordrecht, The Netherlands, 1991. [Google Scholar]
- Buckley, P.M.; DeWilde, T.N.; Reed, B.M. Characterization and identification of bacteria isolated from micropropagated mint plants. Vitr. Cell. Dev. Biol. Plant 1995, 31, 58–64. [Google Scholar] [CrossRef]
- Fellner, M.; Kneifel, W.; Gregorits, D.; Leonhardt, W. Identification and antibiotic sensitivity of microbial contaminants from callus cultures of garlic Allium sativum L. and Allium longicuspis Regei. Plant Sci. 1996, 113, 193–201. [Google Scholar] [CrossRef]
- Taylor, P.W.J. In vitro germplasm conservation of sugarcane cultivars, basic sugarcane species, and related genera. Plant Mol. Genet. Germplasm Dev. Group 1997, 8, 243–256. [Google Scholar]
- Msogoya, T.; Kanyagha, H.; Mutigitu, J.; Kulebelwa, M.; Mamiro, D. Identification and management of microbial contaminants of banana in vitro cultures. J. Appl. Biosci. 2012, 55, 3987–3994. [Google Scholar]
- Altan, F.; Bürün, B.; Sahin, N. Fungal contamination observed during micropropagation of Lilium candidum (L.) and the effect of chemotherapeutic substances applied after sterilization. Afr. J. Biotechnol. 2010, 9, 991–995. [Google Scholar]
- Vichitra, A.; Bakshi, M.; Harsh, N.S.K. Identification and bioassay of fungal contaminants observed during in vitro propagation of Saraca asoka (Roxb.). Wilde. Biotech Int. 2014, 7, 35–42. [Google Scholar]
- Wagih, M.E.; Adkins, S.W.; Attia, K. Establishment of mature axillary bud culture of sugarcane and overcoming persistent culture contamination. Indian J. Sci. Technol. 2009, 2, 18–25. [Google Scholar] [CrossRef]
- Wojtania, A.; Pulawska, J.; Gabryszewska, E. Identification and elimination of bacterial contaminants from Pelargonium tissue cultures. J. Fruit Ornam. Plant Res. 2005, 13, 101–108. [Google Scholar]
- Jena, R.C.; Samal, K.C. Endogenous microbial contaminants during in vitro culture of sweet potato [Ipomoea batatas (L.) Lam]: Identification and prevention. J. Agric. Technol. 2011, 7, 1725–1731. [Google Scholar]
- Misra, P.; Gupta, N.; Toppo, D.D.; Pandey, V.; Mishra, M.K.; Tuli, R. Establishment of long-term proliferating shoot cultures of elite Jatropha curcas L. by controlling endophytic bacterial contamination. Plant Cell Tissue Organ Cult. (PCTOC) 2009, 100, 189–197. [Google Scholar] [CrossRef]
- Venkatasalam, E.P.; Pandey, K.K.; Singh, B.P.; Vandana, T.; Sharma, S.; Sood, R.; Sharma, A.K. Efficacy of antimicrobial agents on in vitro micropropagation potential of potato. Potato J. 2013, 40, 45–54. [Google Scholar]
- Rahman, M.Z.; Islam, S.M.S.; Chowdhury, A.N.; Subramaniam, S. Identification and prevention of microbial contaminants of potato culture in temporary immersion bioreactor (TIB) system. Malays. J. Microbiol. 2017, 13, 289–297. [Google Scholar]
- Eed, A.M.; Reddy, S.A.; Reddy, K.M.; Teixeira da Silva, J.A.; Reddy, P.V.; Beghum, H.; Venkatsubbaiah, P.Y. Effect of antibiotics and fungicides on the in vitro production of Citrus limonia Osbeck nodal segment and shoot tip explants. Asian Australas. J. Plant Sci. Biotechnol. 2010, 4, 66–70. [Google Scholar]
- Patel, B.; Gami, B.; Patel, N.; Bariya, V. One step pre-hardening micropropagation of Bambusa balcooa Roxb. J. Phytol. 2015, 7, 1–9. [Google Scholar] [CrossRef]
- Sharma, P.; Sarma, K.P. In vitro propagation of Bambusa balcooa for a better environment. In Proceedings of the International Conference on Advances in Biotechnology and Pharmaceutical Sciences (ICABPS’2011), Bangkok, Thailand, 23–24 December 2011; pp. 248–252. [Google Scholar]
- Mudoi, K.D.; Borthakur, M. In vitro micropropagation of Bambusa balcooa Roxb. through nodal explants from field-grown culms and scope for upscaling. Curr. Sci. India 2009, 96, 962–966. [Google Scholar]
- Sharma, P.; Sarma, K.P. In vitro propagation of Bambusa nutan in commercial scale in Assam. J. Environ. Res. Dev. 2014, 9, 348–355. [Google Scholar]
- Thakur, R.; Sood, A. An efficient method for explant sterilization for reduced contamination. Plant Cell Tissue Organ Cult. (PCTOC) 2006, 84, 369–371. [Google Scholar] [CrossRef]

| Plate Code | Antibiotic Name | µg/ Disk | Bacterial Isolates on Different Media | |||
|---|---|---|---|---|---|---|
| Trypticase Soy Agar | Potato Dextrose Agar | Middelbrook | R2A | |||
| Bacillus pumilus | Bacillus subtilis | Paenibacillus spp. | Geobacillus stearothermophilus | |||
| Diameter of Inhibition Zone (mm) | ||||||
| 1 | Oxacillin (OX) | 5 | 30 (S) | 32 (S) | 32 (S) | 34 (S) |
| Penicillin G (P) | 6 | 46 (S) | 48 (S) | 50 (S) | 50 (S) | |
| Ampicillin (AMP) | 10 | 44 (S) | 46 (S) | 48 (S) | 48 (S) | |
| 2 | Mezlocillin (MEZ) | 30 | 40 (S) | 46 (S) | 42 (S) | 42 (S) |
| Ticarcillin (TIC) | 75 | 50 (S) | 50 (S) | 55 (S) | 55 (S) | |
| Cefalotin (KF) | 30 | 48 (S) | 50 (S) | 50 (S) | 55 (S) | |
| 3 | Aztreonam(ATM) | 30 | 6 (R) | 0 (R) | 0 (R) | 12 (I) |
| Cefotaxim (CTX) | 30 | 32 (S) | 38 (S) | 30 (S) | 34 (S) | |
| Cefazolin (KZ) | 30 | 40 (S) | 42 (S) | 40 (S) | 42 (S) | |
| 4 | Chloramphenicol (C) | 30 | 34 (S) | 36 (S) | 36 (S) | 42 (S) |
| Imipenem (IPM) | 10 | 48 (S) | 52 (S) | 48 (S) | 50 (S) | |
| Tetracyclin (TE) | 30 | 38 (S) | 40 (S) | 40 (S) | 42 (S) | |
| 5 | Vancomycin (VA) | 30 | 24 (S) | 26 (S) | 24 (S) | 28 (S) |
| Gentamycin (CN) | 30 | 28 (S) | 30 (S) | 30 (S) | 32 (S) | |
| Amikacin (AK) | 30 | 30 (S) | 30 (S) | 32 (S) | 34 (S) | |
| 6 | Erythromycin (OFX) | 5 | 30 (S) | 34 (S) | 34 (S) | 34 (S) |
| Lincomycin (MY) | 15 | 24 (S) | 24 (S) | 22 (S) | 24 (S) | |
| Ofloxacin (E) | 15 | 34 (S) | 38 (S) | 36 (S) | 40 (S) | |
| 7 | Colistin (CT) | 10 | 12 (I) | 12 (I) | 12 (I) | 12 (I) |
| Pipemidsäure (PIP) | 20 | 20 (I) | 20 (I) | 22 (S) | 22 (S) | |
| Norfloxaci (NOR) | 10 | 28 (S) | 32 (S) | 32 (S) | 32 (S) | |
| 8 | Polymyxin B (PB) | 300 | 16 (I) | 16 (I) | 16 (I) | 18 (I) |
| Bacitracin (B) | 10 | 8 (R) | 8 (R) | 8 (R) | 8 (R) | |
| Nitrofurantoin (F) | 100 | 22 (S) | 25 (S) | 24 (S) | 24 (S) | |
| 9 | Neomycin (N) | 30 | 24 (S) | 24 (S) | 26 (S) | 28 (S) |
| Kanamycin (K) | 30 | 30 (S) | 32 (S) | 32 (S) | 34 (S) | |
| Doxycyclin (DO) | 30 | 42 (S) | 40 (S) | 40 (S) | 42 (S) | |
| 10 | Fosfomycin (FOS) | 50 | 6 (R) | 0 (R) | 6 (R) | 0 (R) |
| Clindamycin (DA) | 10 | 34 (S) | 32 (S) | 32 (S) | 34 (S) | |
| Ceftriaxone (CRO) | 30 | 32 (S) | 32 (S) | 30 (S) | 36 (S) | |
| 11 | Moxifloxacin (MXF) | 5 | 36 (S) | 36 (S) | 36 (S) | 38 (S) |
| Nystatin (NS) | 100 | 0 (R) | 0 (R) | 0 (R) | 0 (R) | |
| Linezolid (LZD) | 10 | 42 (S) | 42 (S) | 42 (S) | 44 (S) | |
| 12 | Piperacillin/tazobactam( TZP) | 40 | 36 (S) | 38 (S) | 36 (S) | 42 (S) |
| Teicoplanin (TEC) | 30 | 22 (S) | 22 (S) | 22 (S) | 26 (S) | |
| Quinupristin/Dalfopristin (QD) | 15 | 22 (S) | 22 (S) | 24 (S) | 24 (S) | |
| Antibiotic | Concentration (mg·L−1) | Contamination (%) | Shoots (No./Explant) | Leaves (No./Explant) | Length of the Main Shoot (cm) |
|---|---|---|---|---|---|
| Control | 0 | 100.0 a z | 0.0 h | 0.0 f | 0.0 g |
| Ampicillin | 25 | 46.7 c | 7.7 ab | 4.0 ab | 4.7 bc |
| 50 | 23.3 de | 5.7 cd | 3.3 bc | 3.7 cde | |
| 100 | 0.0 f | 4.3 ef | 3.0 cd | 3.0 ef | |
| 200 | 0.0 f | 2.7 g | 2.3 de | 2.3 f | |
| Penicillin | 25 | 28.3 d | 7.3 ab | 3.7 abc | 5.7 ab |
| 50 | 21.7 e | 6.7 bc | 3.3 bc | 4.3 cd | |
| 100 | 0.0 f | 5.0 de | 2.3 de | 3.3 def | |
| 200 | 0.0 f | 2.7 g | 2.0 e | 2.3 f | |
| Ticarcillin | 25 | 53.3 b | 8.3 a | 4.3 a | 6.0 a |
| 50 | 23.3 de | 7.7 ab | 3.7 abc | 5.7 ab | |
| 100 | 0.0 f | 5.0 de | 2.3 de | 3.3 def | |
| 200 | 0.0 f | 3.3 fg | 2.0 e | 2.3 f | |
| Significance y | |||||
| Antibiotic type (A) | * | * | NS | * | |
| Antibiotic concentration (B) | * | * | * | * | |
| A × B | * | NS | NS | NS | |
Publisher’s Note: MDPI stays neutral with regard to jurisdictional claims in published maps and institutional affiliations. |
© 2021 by the authors. Licensee MDPI, Basel, Switzerland. This article is an open access article distributed under the terms and conditions of the Creative Commons Attribution (CC BY) license (https://creativecommons.org/licenses/by/4.0/).
Share and Cite
El-Banna, A.N.; El-Mahrouk, M.E.; Dewir, Y.H.; Farid, M.A.; Abou Elyazid, D.M.; Schumacher, H.M. Endophytic Bacteria in Banana In Vitro Cultures: Molecular Identification, Antibiotic Susceptibility, and Plant Survival. Horticulturae 2021, 7, 526. https://doi.org/10.3390/horticulturae7120526
El-Banna AN, El-Mahrouk ME, Dewir YH, Farid MA, Abou Elyazid DM, Schumacher HM. Endophytic Bacteria in Banana In Vitro Cultures: Molecular Identification, Antibiotic Susceptibility, and Plant Survival. Horticulturae. 2021; 7(12):526. https://doi.org/10.3390/horticulturae7120526
Chicago/Turabian StyleEl-Banna, Antar Nasr, Mohammed Elsayed El-Mahrouk, Yaser Hassan Dewir, Mona Ali Farid, Doaa Mahmoud Abou Elyazid, and Heinz Martin Schumacher. 2021. "Endophytic Bacteria in Banana In Vitro Cultures: Molecular Identification, Antibiotic Susceptibility, and Plant Survival" Horticulturae 7, no. 12: 526. https://doi.org/10.3390/horticulturae7120526
APA StyleEl-Banna, A. N., El-Mahrouk, M. E., Dewir, Y. H., Farid, M. A., Abou Elyazid, D. M., & Schumacher, H. M. (2021). Endophytic Bacteria in Banana In Vitro Cultures: Molecular Identification, Antibiotic Susceptibility, and Plant Survival. Horticulturae, 7(12), 526. https://doi.org/10.3390/horticulturae7120526

